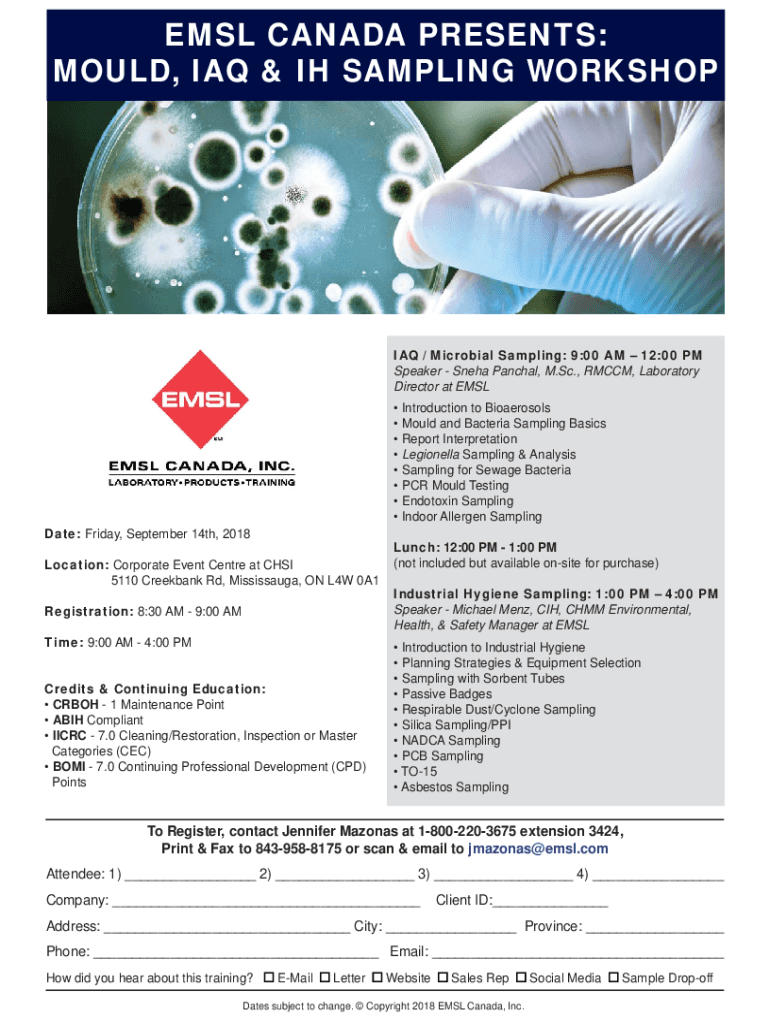

Get the free Basics of Mold Sampling for IAQ Investigations
Show details
EMIL CANADA PRESENTS: Mold, IRAQ & IH SAMPLING WORKSHOP / Microbial Sampling: 9:00 AM 12:00 PM Speaker Sea Paschal, M.Sc., RM CCM, Laboratory Director at EMIL Introduction to Bioaerosols Mold and
We are not affiliated with any brand or entity on this form
Get, Create, Make and Sign basics of mold sampling

Edit your basics of mold sampling form online
Type text, complete fillable fields, insert images, highlight or blackout data for discretion, add comments, and more.

Add your legally-binding signature
Draw or type your signature, upload a signature image, or capture it with your digital camera.

Share your form instantly
Email, fax, or share your basics of mold sampling form via URL. You can also download, print, or export forms to your preferred cloud storage service.
How to edit basics of mold sampling online
Use the instructions below to start using our professional PDF editor:
1
Set up an account. If you are a new user, click Start Free Trial and establish a profile.
2
Prepare a file. Use the Add New button to start a new project. Then, using your device, upload your file to the system by importing it from internal mail, the cloud, or adding its URL.
3
Edit basics of mold sampling. Replace text, adding objects, rearranging pages, and more. Then select the Documents tab to combine, divide, lock or unlock the file.
4
Get your file. Select the name of your file in the docs list and choose your preferred exporting method. You can download it as a PDF, save it in another format, send it by email, or transfer it to the cloud.
With pdfFiller, it's always easy to work with documents.
Uncompromising security for your PDF editing and eSignature needs
Your private information is safe with pdfFiller. We employ end-to-end encryption, secure cloud storage, and advanced access control to protect your documents and maintain regulatory compliance.
How to fill out basics of mold sampling

How to fill out basics of mold sampling
01
Here are the steps to fill out the basics of mold sampling:
02
Prepare the necessary materials for mold sampling, including sampling cassettes, petri dishes, swabs, gloves, and a clean surface to collect samples.
03
Put on gloves to protect yourself from potential mold exposure.
04
Select the area to be sampled. Look for visible signs of mold or areas with a musty odor. You can also choose high-risk areas such as damp basements, crawl spaces, or areas with water damage.
05
Open a sampling cassette and place it in the provided holder. Make sure to keep the lid closed until ready for sampling.
06
To collect an air sample, hold the open cassette with the sampling slot facing towards the area being sampled and let air pass through it for a specified amount of time (usually 5-10 minutes).
07
To collect a surface sample, swipe a sterile swab across the suspected mold growth or the surface where the mold might be present.
08
For bulk sampling, use a clean knife or similar tool to scrape off a small sample of the mold and place it into a clean bag or container.
09
Label each sample with a unique identifier, such as the location or sample number, to track them accurately.
10
Document the sampling details, including the date, location, and any observations related to the sampling process or the area being sampled.
11
Seal the samples properly to avoid cross-contamination and protect them during transportation.
12
Send the samples to a qualified laboratory for analysis and interpretation of the results.
13
Remember to follow proper safety precautions and consult with experts if needed during the mold sampling process.
Who needs basics of mold sampling?
01
Basics of mold sampling are needed by professionals and individuals involved in indoor air quality assessment, such as:
02
- Environmental consultants
03
- Industrial hygienists
04
- Building inspectors
05
- Mold remediation contractors
06
- Homeowners dealing with mold problems
07
- Tenants concerned about mold in their rented properties
08
- Health professionals evaluating potential mold exposure cases
09
- Researchers studying mold and its effects on human health
10
Having a basic understanding of mold sampling helps in identifying and assessing potential mold issues, determining appropriate remediation strategies, and ensuring a healthy indoor environment.
Fill
form
: Try Risk Free






For pdfFiller’s FAQs
Below is a list of the most common customer questions. If you can’t find an answer to your question, please don’t hesitate to reach out to us.
Can I sign the basics of mold sampling electronically in Chrome?
Yes, you can. With pdfFiller, you not only get a feature-rich PDF editor and fillable form builder but a powerful e-signature solution that you can add directly to your Chrome browser. Using our extension, you can create your legally-binding eSignature by typing, drawing, or capturing a photo of your signature using your webcam. Choose whichever method you prefer and eSign your basics of mold sampling in minutes.
Can I create an electronic signature for signing my basics of mold sampling in Gmail?
Create your eSignature using pdfFiller and then eSign your basics of mold sampling immediately from your email with pdfFiller's Gmail add-on. To keep your signatures and signed papers, you must create an account.
How can I edit basics of mold sampling on a smartphone?
You can easily do so with pdfFiller's apps for iOS and Android devices, which can be found at the Apple Store and the Google Play Store, respectively. You can use them to fill out PDFs. We have a website where you can get the app, but you can also get it there. When you install the app, log in, and start editing basics of mold sampling, you can start right away.
What is basics of mold sampling?
Basics of mold sampling refers to the techniques and procedures used to collect samples of mold in order to assess its presence and concentration in an environment.
Who is required to file basics of mold sampling?
Typically, property owners, employers, and organizations involved in construction or renovation work are required to file mold sampling reports, especially if mold presence is suspected.
How to fill out basics of mold sampling?
To fill out mold sampling documentation, one must collect the samples according to guidelines, record data about the locations and conditions of sampling, and provide any relevant environmental information.
What is the purpose of basics of mold sampling?
The purpose of mold sampling is to identify the type and concentration of mold in a given area to evaluate potential health risks and the need for remediation.
What information must be reported on basics of mold sampling?
Reports should include the sampling locations, types of mold identified, concentrations, date of sampling, environmental conditions, and any actions taken.
Fill out your basics of mold sampling online with pdfFiller!
pdfFiller is an end-to-end solution for managing, creating, and editing documents and forms in the cloud. Save time and hassle by preparing your tax forms online.
Basics Of Mold Sampling is not the form you're looking for?Search for another form here.
Relevant keywords
Related Forms
If you believe that this page should be taken down, please follow our DMCA take down process
here
.
This form may include fields for payment information. Data entered in these fields is not covered by PCI DSS compliance.





















